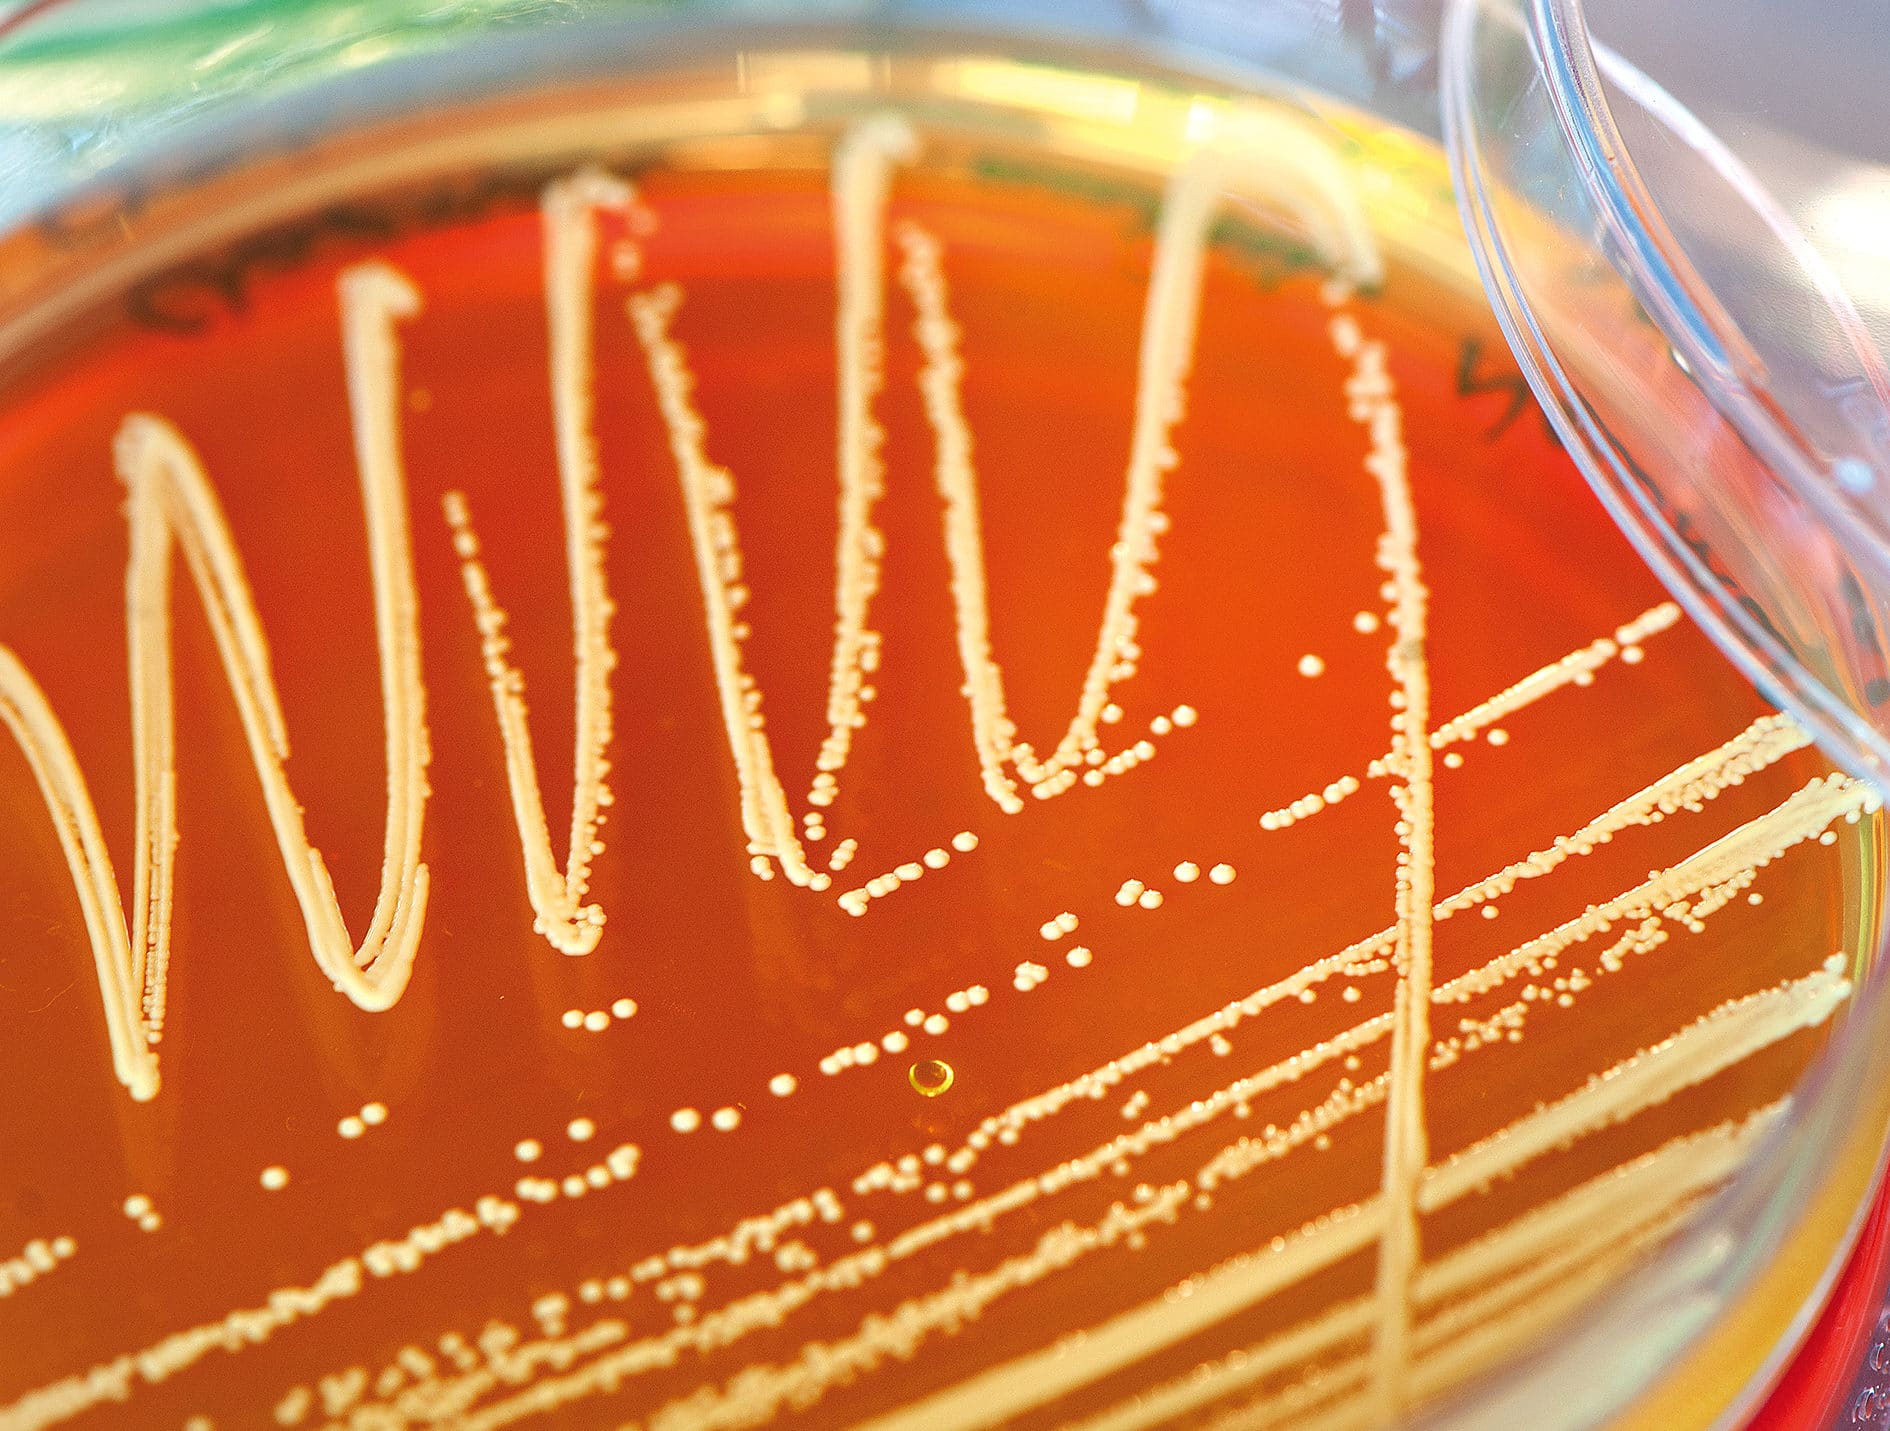

Lauréat·e·s des prix scientifiques

Prix scientifique 2025
Innovation dans la prise en charge des mutilations génitales féminines

Prix scientifique 2025
Rigidifier les cellules cancéreuses pour mieux les éliminer

Prix scientifique 2024
Maladie à corps de Lewy

Prix scientifique 2024
Traiter grâce aux virus antibactériens

Prix scientifique 2023
Combattre les infections postopératoires en urologie

Prix scientifique 2023
Des citoyen.ne.s lausannois.e.s pour mieux comprendre les maladies cardiovasculaires

Prix scientifique 2023
S’attaquer aux symptômes négatifs de la schizophrénie

Prix scientifique 2022
Obésité et arthrose

Prix scientifique 2021
Interface cerveau-moelle épinière pour retrouver l’usage des jambes

Prix scientifique 2021
Réveiller le système immunitaire pour lutter contre le cancer lymphatique

Prix scientifique 2020
Bloquer les réactions inflammatoires contre notre propre ADN : un traitement innovant des maladies auto-immunes.

Prix scientifique 2019
Coordonner les mouvements de la maman et du bébé pour favoriser les accouchements par voie basse

Prix scientifique 2019
Dormir et manger en harmonie avec ses horloges internes

Prix scientifique 2018
Améliorer la santé mentale des adolescents par la méditation en pleine conscience

Prix scientifique 2018
Facteurs socio-économiques: quel impact sur le vieillissement du cerveau?

Prix scientifique 2017
Sclérose en plaques et cholestérol : le chemin de la trahison

Prix scientifique 2016
Combattre les virus respiratoires grâce au monde de l'infiniment petit

Prix scientifique 2016
Retrouver ses repères spatiaux après un AVC grâce à la « physiothérapie » du cerveau

Prix scientifique 2015
Génome contre génome : l’impact des variations génétiques humaines sur les infections virales chroniques

Prix scientifique 2015
Performance physique au quotidien chez l’enfant avec une paralysie cérébrale. Combler le fossé entre le laboratoire et le quotidien

Prix scientifique 2014
Approche thérapeutique et diagnostique pour délivrer de la chimiothérapie de manière ciblée

Prix scientifique 2014
Les auto-anticorps anti-apoA-1 comme marqueur pronostique du risque cardiovasculaire et nouvelle cible thérapeutique

Prix scientifique 2013
Cibler l’angiogenèse et les réseaux immunosuppresseurs pour améliorer le traitement des cancers du sein et de l’ovaire

Prix scientifique 2013
Le génome de l’hôte et sa transcription : nouvelles approches pour le diagnostic et le traitement des infections fongiques

Prix scientifique 2012
Diriger les gènes pour explorer et réparer les circuits du cerveau

Prix scientifique 2012
Orchestration de l’expression génique par l’horloge circadienne

Prix scientifique 2012
Suppression de la réponse immunitaire par les microbes intestinaux

Prix scientifique 2011
Comment éviter que les tumeurs rendent le système immunitaire tolérant ?

Prix scientifique 2011
Etude des mystérieux mécanismes de division et de différenciation des chlamydiae

Prix scientifique 2011
Les vaisseaux lymphatiques comme cibles thérapeutiques
Prix scientifique 2010
Façonnage du système immunitaire par des infections virales

Prix scientifique 2010
Un modèle génétique pour l’étude de l’obésité, de l’autisme et de la schizophrénie

Prix scientifique 2009
Etude des mécanismes amenant des pathogènes à être mortels pour l’homme

Prix scientifique 2009
Nouvelle approche thérapeutique de certaines maladies inflammatoires et tumorales de la peau

Prix scientifique 2008
Déterminants génétiques de l’histoire naturelle de l’hépatite C et de la réponse au traitement antiviral

Prix scientifique 2008
Développement d’une nouvelle méthode d’imagerie

Prix scientifique 2008
Le rôle de la molécule APRIL dans le diagnostic et le traitement du type le plus répandu de lymphome

Prix scientifique 2007
La levure de boulanger: un modèle unique

Prix scientifique 2007
Le devenir des enfants prématurés

Prix scientifique 2007
Mieux comprendre la formation d’un caillot sanguin

Prix scientifique 2006
Etude de la progression de l’hépatite C

Prix scientifique 2006
Etude de l’évolution de l’hépatite C

Prix scientifique 2005
Recherche sur le rôle des cellules souches

Prix scientifique 2005
Recherche sur les interactions multisensorielles

Prix scientifique 2004
Désarmer le mélanome

Prix scientifique 2004
La dépendance au plaisir: pourquoi?

Prix scientifique 2004
Pour régénérer les cœurs malades
Prix scientifique 2003
Communication olfactive entre mammifères

Prix scientifique 2003
Des excursions transcendantales à la médecine moderne

Prix scientifique 2003
Des nouveau-nés à risque

Prix scientifique 2003
Une protéine clé et les secrets de la mémoire

Prix scientifique 1999

